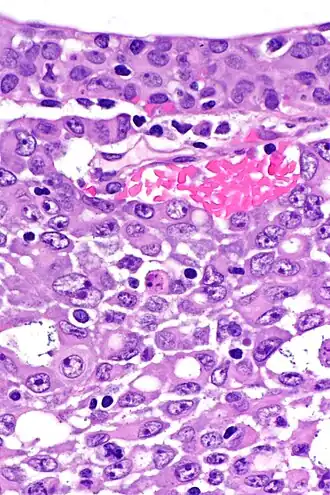
Типичная гистологическая картина медуллярного рака почки в высоком разрешении. Окраска гематоксилином и эозином.

Медуллярный рак почки
| Медуллярный рак почки | |
|---|---|
![]() Типичная гистологическая картина медуллярного рака почки в высоком разрешении. Окраска гематоксилином и эозином. | |
| МКБ-10-КМ | C64 |
Медуллярный рак почки — довольно редкая, чрезвычайно агрессивная, быстро растущая, в силу очень быстрого митотического деления клеток, а также быстро метастазирующая, форма рака почки. Чаще всего она развивается у подростков и молодых людей, преимущественно принадлежащих к негроидной расе или, реже, у мулатов (средний возраст на момент постановки диагноза — около 28 лет), являющихся условно здоровыми гетерозиготными носителями аутосомно-рецессивного гена серповидно-клеточной анемии, или, что наблюдается гораздо реже, гомозиготными пациентами, клинически явно страдающими этой формой наследственной гемоглобинопатии[1][2][3][4].
Эпидемиология медуллярного рака почки
Подавляющее большинство первично диагностированных пациентов с медуллярным раком почки — подростки или молодые люди, преимущественно негроидной расы или, реже, мулаты. Средний возраст пациентов на момент постановки диагноза — 28 лет. Большинство страдающих медуллярным раком почки — являются условно здоровыми гетерозиготными носителями аутосомно-рецессивного гена серповидно-клеточной анемии, либо, реже, являются гомозиготными пациентами, клинически явно страдающими этой формой наследственной гемоглобинопатии[1][2][3][4].
По состоянию на 2009 год, во всём мире было официально диагностировано всего около 120 случаев медуллярного рака почки. Почти во всех описанных к 2009 году в мировой медицинской литературе случаях, кроме одного-единственного случая, у пациентов с медуллярным раком почки отмечалось либо гетерозиготное носительство гена серповидно-клеточной анемии, либо гомозиготный (болезненный) статус по этому гену, либо какая-то другая из наследственных гемоглобинопатий, потенциально могущих приводить или фактически приводящих к развитию серповидной деформации эритроцитов в условиях гипоксии[1][2][3][4].
Опухоль Вильмса, самая частая из злокачественных опухолей почек в детском возрасте, ответственна за 6-7 % от всех видов злокачественных опухолей (из разных органов и тканей) у детей, и за более чем 90 % от всех злокачественных первичных опухолей почек у детей[1][2][3][4].
В то же время все остальные разновидности первичного рака почки (включая и медуллярный рак почки), вместе взятые, ответственны менее чем за 1 % от всех случаев злокачественных опухолей детского возраста (из любых органов и тканей), и менее чем за 10 % от всех злокачественных первичных опухолей почек у детей[1][2][3][4].
Клиническая симптоматика медуллярного рака почки
В 1995 году в своём пионерском описании серии из первых 34 клинических случаев медуллярного рака почки, собранных ими за 22 года наблюдений, Дэвис с коллегами отметили, что на момент постановки первичного диагноза у описанных ими пациентов чаще всего наблюдались следующие клинические симптомы и лабораторные признаки болезни[1][2][3][4]:
- Макроскопически (невооружённым глазом) видимая гематурия (в 60 % от всех описанных ими случаев);
- Боль в животе или в нижней части спины, в пояснице, иногда с иррадиацией в таз, промежность и/или в бедро и ниже (в 50 % от всех описанных ими случаев);
- Значительное снижение массы тела и/или аппетита (в 25 % от всех описанных ими случаев);
- Могли также наблюдаться разнообразные симптомы, связанные с метастазированием в отдалённые органы (например, кашель и кровохарканье при метастазах в лёгкие, нарушения психики и поведения при метастазах в головной мозг, параличи при метастазах в спинной мозг).
Более поздние исследователи отметили, что при медуллярном раке почки к моменту постановки первичного диагноза могут также обнаруживаться пальпируемые первичные опухолевые массы в области почек или пальпируемые их метастазы в брюшной полости, а также увеличение лимфатических узлов, иногда — опухолевый асцит.
Генетические особенности медуллярного рака почки
Ген SMARCB1, с поломкой (полной или частичной делецией или миссенс-мутацией) которого в медуллярной ткани почки связывают развитие медуллярного рака почки, находится на хромосоме 22[1][2][3][4][5].
Гипотезы о патогенезе (механизме развития) медуллярного рака почки
Основными патогенетическими факторами для развития медуллярного рака почки, как предположили в 2018 году д-р Павлос Мсауль, д-р Низар Таннир и д-р Шерил Лин Уокер, являются гипоксия и гиперосмолярность ткани почечной медуллы[6].
Известные факторы риска развития медуллярного рака почки
Помимо принадлежности к негроидной расе или, реже, к мулатам (то есть к смешанной негроидно-европеоидной расе), а также гетерозиготного условно-здорового носительства или, реже, гомозиготного (болезненного) статуса по гену серповидно-клеточной анемии, к известным факторам риска или факторам, предрасполагающим к развитию медуллярного рака почки, относятся также большие физические нагрузки, например, тяжёлый физический труд, сопряжённый с большой мышечной (механической) работой и большими затратами энергии, или чрезмерное увлечение спортом, особенно его силовыми видами в анаэробном режиме (то есть, при уровне нагрузки заведомо выше анаэробного порога)[2][3][4].
Лечение медуллярного рака почки
Лечение медуллярного рака почки, как правило, начинается с применения специфической для данного вида рака неоадъювантной цитостатической химиотерапии. Только после достижения регресса первичной опухоли и исчезновения метастазов на фоне химиотерапии — производится хирургическое удаление пораженной почки (нефрэктомия). Эта последовательность противоположна обычной для многих других форм почечноклеточного рака последовательности «сначала нефрэктомия, а уже после неё — адъювантная химиотерапия»[1][2][3][4].
Первой линией неоадъювантной цитостатической химиотерапии при медуллярном раке почки по состоянию на 2021 год считается применение одного из препаратов платины (цитостатика алкилирующего типа) в комбинации с антиметаболитом гемцитабином и с антрациклиновым противоопухолевым антибиотиком (по механизму действия — интеркалантом ДНК и ингибитором топоизомеразы II) доксорубицином[1][2][3][4].
Специфическая таргетная терапия и иммунотерапия, эффективные при большинстве других видов почечноклеточного рака, в частности, при наиболее распространённом светлоклеточном раке почки — при медуллярном раке почки неэффективны[1][2][3][4].
Прогноз медуллярного рака почки
Несмотря на значительные усовершенствования как в вопросах более ранней диагностики, так и в методах лечения медуллярного рака почки в последние десятилетия, прогноз для большинства пациентов с этой формой почечноклеточного рака всё ещё остаётся очень плохим. Общая трёхлетняя (даже не пятилетняя!) выживаемость пациентов с медуллярным раком почки, по состоянию на 2021 год, составляет всего 3 %, а частота положительного ответа на применение цитостатической химиотерапии первой линии (то есть на лечение комбинацией одного из препаратов платины с гемцитабином и доксорубицином) — всего 29 %[2][3][4].
История открытия
Исторически первое упоминание в мировой медицинской литературе о медуллярном раке почки относится к 1990 году и исходит из Швейцарии. В этом сообщении автор описывает единственный известный на тот момент клинический случай медуллярного рака почки с двусторонним поражением обеих почек, постоянной микрогематурией (постоянным выделением форменных элементов крови с мочой) и правосторонним нефроптозом (опущением правой почки, по сравнению с её нормальным анатомическим положением) у молодой женщины, перенёсшей до этого гистерэктомию (хирургическое удаление матки) по поводу множественных миом матки[7].
А в 1995 году другая группа авторов опубликовала обобщённые результаты своих 22-летних наблюдений за 34-мя пациентами с необычно агрессивной формой почечноклеточного рака, морфологические характеристики которого достаточно сильно напоминали рак почки, развивающийся из клеток собирательных трубочек (англ. collecting duct carcinoma), но отличались тем, что позволяли заранее предсказать обнаружение в биоптатах ткани этой злокачественной опухоли серповидно-клеточно деформированных эритроцитов. Все описанные авторами этой статьи пациенты, кроме одного (то есть 33 из 34 пациентов) — были гетерозиготными условно здоровыми носителями аутосомно-рецессивного гена серповидно-клеточной анемии, а один пациент был гомозиготным больным с серповидно-клеточной анемией. Все пациенты, расовая принадлежность и этническое происхождение которых были достоверно известны авторам статьи — были либо негроидной расы, либо мулатами. Их возраст на момент первичной постановки диагноза варьировал от 11 до 39 лет. Средний же возраст пациентов из этой выборки составлял около 22 лет на момент первичной постановки диагноза[2][3][4][8].
В этой выборке из 34 пациентов в возрастной подгруппе от 11 до 24 лет отмечалось резкое преобладание пациентов мужского пола (то есть мальчиков-подростков, юношей и молодых мужчин), в соотношении 3:1. Вместе с тем, в возрастной подгруппе более старших пациентов из этой выборки — в подгруппе от 25 до 39 лет — соотношение мужчин и женщин было одинаковым (1:1). Доминантная опухолевая масса обнаруживалась в медуллярной ткани почки. На момент первичной постановки диагноза её размер варьировал от 4 до 12 см в диаметре. Средний диаметр первичной опухолевой массы на момент постановки диагноза в этой выборке пациентов составлял 7 см, а медианный — 6 см. К моменту постановки диагноза у подавляющего большинства пациентов уже наблюдались как метастазы в окружающие ткани (в ткань коры почки, в мягкие ткани таза, в ближайшие лимфатические сосуды, лимфатические узлы и вены), так и отдалённые метастазы. К моменту проведения нефрэктомии у всех 34 пациентов опухолевое поражение уже не ограничивалось одной лишь только почкой, где возникла первичная опухоль. Средняя продолжительность жизни пациентов после нефрэктомии в этой выборке составила всего 15 недель — намного меньше, чем при большинстве других видов рака почки[2][3][4][8].
Гистологически эти опухолевые поражения имели либо вид ретикулярных опухолей, напоминающих злокачественные опухоли, происходящие из желточного мешка, либо вид аденоидно-кистозных опухолей. Часто отмечались островки низкодифференцированной опухолевой ткани, с сильно десмопластической стромой. Отмечались выраженная воспалительная реакция как в самой ткани опухоли, так и в окружающих её тканях, внутриопухолевый и перифокальный отёк, инфильтрация ткани опухоли нейтрофильными гранулоцитами, а также окаймление её воспалительным «валиком» из лимфоцитов[8].
Авторы этой статьи предположили, что эта разновидность почечноклеточного рака, скорее всего, развивается из тканей дистальных концов нефрона, а конкретно — из ткани эпителия чашечек в сосочках почек или где-то рядом с этим местом — то есть, в тех же местах нефрона, повреждение которых обычно вызывает одностороннюю или двустороннюю гематурию у гетерозиготных условно здоровых носителей гена серповидно-клеточной анемии. Они также предположили, что медуллярный рак почки, по-видимому, является или может являться ещё одним, седьмым по счёту, вариантом поражения почек, которое может развиться у гетерозиготных условно здоровых носителей гена серповидно-клеточной анемии. Другие шесть уже известных, ранее описанных, вариантов поражения почек у таких пациентов — это односторонняя или, реже, двусторонняя гематурия, папиллярный (сосочковый) некроз одной или, реже, обеих почек, нефротический синдром с протеинурией (выделением белка с мочой), инфаркт одной или, реже, обеих почек, снижение способности почек концентрировать мочу и пиелонефрит (воспаление почечной лоханки)[2][3][4][8].
Именно это описание от 1995 года ныне считается моментом официального введения медуллярного рака почки, как отдельной нозологической единицы, в современную классификацию злокачественных опухолей почек[2][3][4].
Примечания
- 1 2 3 4 5 6 7 8 9 10 B. Ljungberg (председатель), L. Albiges, K. Bensalah, A. Bex (вице-председатель), R.H. Giles (адвокат пациентов), M. Hora, M.A. Kuczyk, T. Lam, L. Marconi, A.S. Merseburger, T. Powles, M. Staehler, A. Volpe. Клинические рекомендации по почечноклеточному раку от 2018 года, русскоязычный перевод (2018). Дата обращения: 20 августа 2021. Архивировано 20 августа 2021 года.
- 1 2 3 4 5 6 7 8 9 10 11 12 13 14 15 16 Chubbyemu (Dr. Bernard), Dr. Bernard; Chubbyemu, Dr. Bernard. A Man Felt Pain In His Back. This Is What Happened To His Kidney. (англ.). YouTube Channel "Chubbyemu". youtube.com (19 августа 2021). Дата обращения: 20 августа 2021. Архивировано 20 августа 2021 года.
- 1 2 3 4 5 6 7 8 9 10 11 12 13 14 15 16 Chubbyemu (Dr. Bernard), Dr. Bernard; Chubbyemu, Dr. Bernard. A Brief Discussion On Renal Medullary Carcinoma (англ.). YouTube Channel "Heme Review". youtube.com (19 августа 2021). Дата обращения: 20 августа 2021. Архивировано 19 августа 2021 года.
- 1 2 3 4 5 6 7 8 9 10 11 12 13 14 15 16 Chubbyemu (Dr. Bernard), Dr. Bernard; Chubbyemu, Dr. Bernard. An Athlete Squatted 500 Reps In 20 Minutes. This Is What Happened To His Kidneys. (англ.). YouTube Channel "Chubbyemu". youtube.com (18 января 2020). Дата обращения: 20 августа 2021. Архивировано 20 августа 2021 года.
- ↑ Pavlos Msaouel, Nizar Tannir, Cheryl Lyn Walker. A Model Linking Sickle Cell Hemoglobinopathies and SMARCB1 Loss in Renal Medullary Carcinoma : [англ.] : [арх. 20 августа 2021] // Clinical cancer research : an official journal of the American Association for Cancer Research. — 2018. — Vol. 24, no. 9 (1 May). — P. 2044—2049. — doi:10.1158/1078-0432.CCR-17-3296. — PMID 29440190.
- ↑ Pavlos Msaouel, Nizar M. Tannir, Cheryl Lyn Walker. A Model Linking Sickle Cell Hemoglobinopathies and SMARCB1 Loss in Renal Medullary Carcinoma : [англ.] // Clinical Cancer Research. — 2018. — Vol. 24, no. 9 (1 May). — P. 2044-2049. — doi:10.1158/1078-0432.CCR-17-3296.
- ↑ Bohni B. A case from practice (203). Bilateral renal medullary carcinoma with persistent microhematuria, right-sided nephroptosis without obstruction. Status following hysterectomy for uterine myomatosis : [нем.] : [арх. 20 августа 2021] // Schweizerische Rundschau für Medizin Praxis = Revue suisse de médecine Praxis. — 1990. — Vol. 79, no. 50 (Dezember). — P. 1580—1581. — PMID 2270382.
- 1 2 3 4 C J Davis Jr, F K Mostofi, I A Sesterhenn. Renal medullary carcinoma. The seventh sickle cell nephropathy : [англ.] : [арх. 20 августа 2021] // The American Journal of Surgical Pathology. — 1995. — Vol. 19, no. 1 (January). — P. 1—11. — doi:10.1097/00000478-199501000-00001. — PMID 752847.